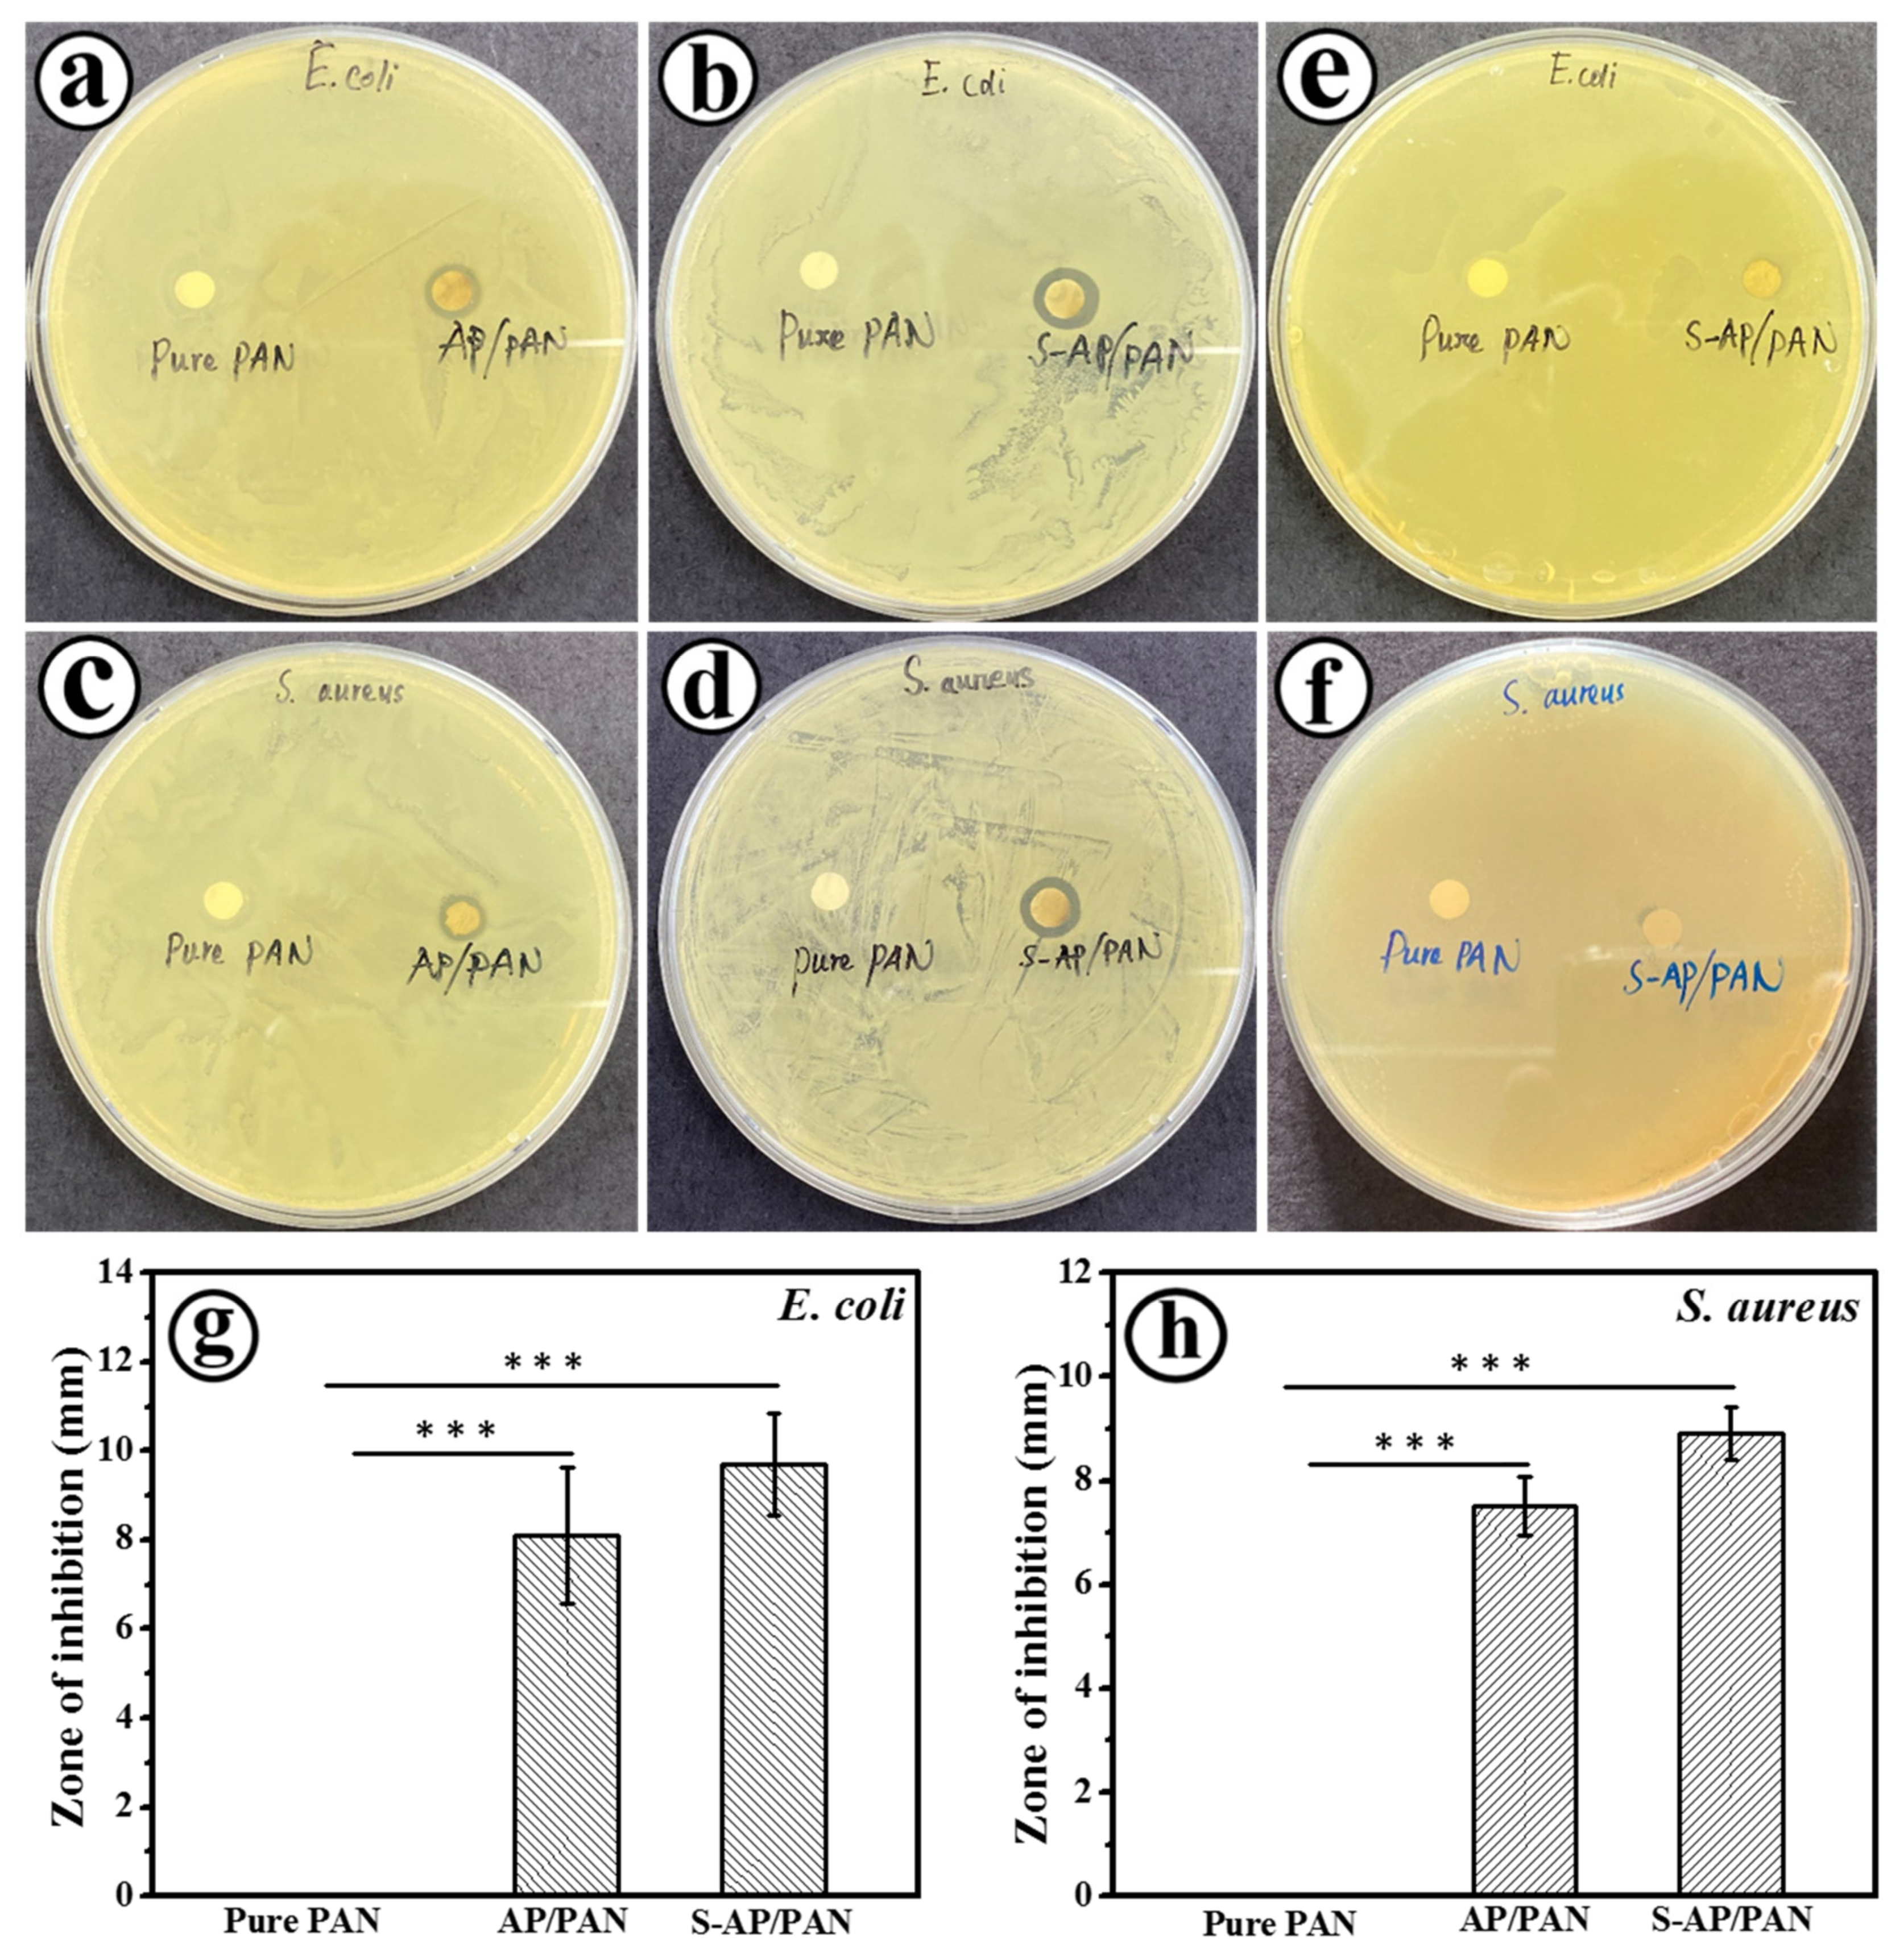
Molecules 25 01411 g007 Molecules 25 01411 g007

Enhanced Antibacterial Property of Sulfate-Doped Ag3PO4 Nanoparticles Supported on PAN Electrospun Nanofibers
Abstract
1. Introduction
2. Results and Discussion
3. Materials and Methods
3.1. Chemicals
3.2. Fabrication of Na2HPO4/PAN Nanofibers
3.3. Fabrication of Sulfate Doped Ag3PO4/PAN (SO42−-Ag3PO4/PAN) Heterojunction Nanofibers
3.4. Characterization
3.5. Antibacterial Activity Investigation
3.6. Statistical Analysis
4. Conclusions
Author Contributions
Funding
Conflicts of Interest
References
- Thompson, J.M.; Gündogdu, A.; Stratton, H.M.; Katouli, M. Antibiotic resistant Staphylococcus aureus in hospital wastewaters and sewage treatment plants with special reference to methicillin-resistant Staphylococcus aureus (MRSA). J. Appl. Microbiol. 2013, 114, 44–52. [Google Scholar] [CrossRef] [PubMed]
- Goldstein, R.E.R.; Micallef, S.A.; Gibbs, S.G.; Davis, J.A.; He, X.; George, A.; Kleinfleter, L.M.; Schreiber, N.A.; Mukherjee, S.; Sapkota, S.W.; et al. Methicillin-resistant Staphylococcus aureus (MRSA) detected at four U.S. wastewater treatment plants. Environ. Health Perspect. 2012, 120, 1551–1558. [Google Scholar] [CrossRef] [PubMed]
- Raita, M.S.; Iconaru, S.L.; Groza, A.; Cimpeanu, C.; Predoi, G.; Ghegoiu, L.; Badea, M.L.; Chifiriuc, M.C.; Marutescu, L.; Trusca, R.; et al. Multifunctional hydroxyapatite coated with Arthemisia absinthium composites. Molecules 2020, 25, 413. [Google Scholar] [CrossRef] [PubMed]
- Fleming, A. Classics in infectious diseases: On the antibacterial action of cultures of a penicillium with special reference to their isolation of B. influenza. Rev. Infect. Dis. 1929, 2, 129–139. [Google Scholar] [CrossRef]
- Costanzo, S.D.; Murby, J.; Bates, J. Ecosystem response to antibiotics entering the aquatic environment. Mar. Pollut. Bull. 2005, 51, 218–223. [Google Scholar] [CrossRef]
- Watkinson, A.J.; Murby, E.J.; Kolpin, D.W.; Costanzo, S.D. The occurrence of antibiotics in an urban watershed: From wastewater to drinking water. Sci. Total Environ. 2009, 407, 2711–2723. [Google Scholar] [CrossRef] [PubMed]
- Ireland, J.C.; Klostermann, P.; Rice, E.W.; Clark, R.M. Inactivation of Escherichia coli by titanium dioxide photocatalytic oxidation. Appl. Environ. Microbiol. 1993, 59, 1668–1670. [Google Scholar] [CrossRef]
- Maness, P.C.; Smolinski, S.; Blake, D.M.; Huang, Z.; Wolfrum, E.J.; Jacoby, W.A. Bactericidal activity of photocatalytic TiO2 reaction: Toward an understanding of its killing mechanism. Appl. Environ. Microbiol. 1999, 65, 4094–4098. [Google Scholar] [CrossRef]
- Sun, L.; Qin, Y.; Cao, Q.Q.; Hu, B.Q.; Huang, Z.W.; Ye, L.; Tang, X.F. Novel photocatalytic antibacterial activity of TiO2 microspheres exposing 100% reactive {111} facets. Chem. Commun. 2011, 47, 12628–12630. [Google Scholar] [CrossRef]
- Panthi, G.; Barakat, N.A.M.; Al-Deyab, S.S.; El-Newehy, M.; Pandeya, D.Y.; Kim, H.K. Interior synthesizing of ZnO nanoflakes inside nylon-6 electrospun nanofibers. J. Appl. Polym. Sci. 2013, 127, 2025–2032. [Google Scholar] [CrossRef]
- Piccirillo, C.; Pinto, R.A.; Tobaldi, D.M.; Pullar, R.C.; Labrincha, J.A.; Pintado, M.M.E.; Castro, P.M.L. Light induced antibacterial activity and photocatalytic properties of Ag/Ag3PO4 -based material of marine origin. J. Photochem. Photobiol. A 2015, 296, 40–47. [Google Scholar] [CrossRef]
- Thiyagarajan, S.; Singh, S.; Bahadur, D. Reusable sunlight activated photocatalyst Ag3PO4 and its significant antibacterial activity. Mater. Chem. Phys. 2016, 173, 385–394. [Google Scholar] [CrossRef]
- Liu, W.; Shen, J.; Yang, X.; Liu, Q.; Tang, H. Dual Z-Scheme gC3N4/Ag3PO4/Ag2MoO4 ternary composite photocatalyst for solar oxygen evolution from water splitting. Appl. Surf. Sci. 2018, 456, 369–378. [Google Scholar] [CrossRef]
- Yi, Z.; Ye, J.; Kikugawa, N.; Kako, T.; Ouyang, S.; Williams, H.S.; Yang, H.; Cao, J.; Luo, W.; Li, Z. An orthophosphate semiconductor with photooxidation properties under visible-light irradiation. Nat. Mater. 2010, 9, 559–564. [Google Scholar] [CrossRef]
- Xu, J.W.; Gao, Z.D.; Han, K.; Liu, Y.; Song, Y.Y. Synthesis of magnetically separable Ag3PO4/TiO2/Fe3O4 heterostructure with enhanced photocatalytic performance under visible light for photoinactivation of bacteria. Acs Appl. Mater. Interfaces 2014, 6, 15122–15131. [Google Scholar] [CrossRef]
- Lin, W.; Zhang, S.; Wang, D.; Zhang, C.; Sun, D. Ultrasound-assisted synthesis of high-efficiency Ag3PO4/CeO2 heterojunction photocatalyst. Ceram. Int. 2015, 41, 8956–8963. [Google Scholar] [CrossRef]
- Yang, X.; Qin, J.; Jiang, Y.; Li, R.; Li, Y.; Tang, H. Bifunctional TiO2/Ag3PO4/graphene composites with superior visible light photocatalytic performance and synergistic inactivation of bacteria. Rsc Adv. 2014, 4, 18627–18636. [Google Scholar] [CrossRef]
- Liang, Q.; Shi, Y.; Ma, W.; Li, Z.; Yang, X. Enhanced photocatalytic activity and structural stability by hybridizing Ag3PO4 nanospheres with graphene oxide sheets. Phys. Chem. Chem. Phys. 2012, 14, 15657–15665. [Google Scholar] [CrossRef]
- Tian, J.; Li, H.; Xing, Z.; Wang, L.; Asiri, A.M.; Youbi, A.O.A.; Sun, X. Facile synthesis of MWCNTs/Ag3PO4: Novel photocatalysts with enhanced photocatalytic activity under visible light. J. Nanoparticle Res. 2013, 15, 1453–1460. [Google Scholar] [CrossRef]
- Wang, Z.; Yin, L.; Zhang, M.; Zhou, G.; Fei, H.; Shi, H.; Dai, H. Synthesis and characterization of Ag3PO4/multiwalled carbon nanotube composite photocatalyst with enhanced photocatalytic activity and stability under visible light. J. Mater. Sci. 2014, 49, 1585–1593. [Google Scholar] [CrossRef]
- Ma, J.; Zou, J.; Li, L.; Yao, C.; Kong, Y.; Cui, B.; Zhu, R.; Li, D. Nanocomposite of attapulgite-Ag3PO4 for Orange II photodegradation. App. Catal. B Environ. 2014, 144, 36–40. [Google Scholar] [CrossRef]
- Kim, D.S.; Cho, Y.J.; Park, J.; Yoon, J.; Jo, Y.; Jung, M.H. (Mn, Zn) Co-doped CdS nanowires. J. Phys. Chem. C 2007, 111, 10861–10868. [Google Scholar] [CrossRef]
- Chandramohan, S.; Kanjilal, A.; Sarangi, S.N.; Majumder, S.; Sathyamoorthy, R.; Hong, C.H.; Som, T. Effect of substrate temperature on implantation doping of Co in CdS nanocrystalline thin films. Nanoscale 2010, 2, 1155–1159. [Google Scholar] [CrossRef] [PubMed]
- Li, J.X.; Xu, J.H.; Dai, W.L.; Li, H.X.; Fan, K.N. Direct hydro-alcohol thermal synthesis of special core-shell structured Fe-doped titania microspheres with extended visible light response and enhanced photoactivity. Appl. Catal. B 2009, 85, 162–170. [Google Scholar] [CrossRef]
- Zhang, S.N.; Zhang, S.J.; Song, L.M. Super-high activity of Bi3+ doped Ag3PO4 and enhanced photocatalytic mechanism. Appl. Catal. B Environ. 2014, 152, 129–139. [Google Scholar] [CrossRef]
- Xie, Y.P.; Wang, G.S. Visible light responsive porous Lanthanum-doped Ag3PO4 photocatalyst with high photocatalytic water oxidation activity. J. Colloid Interface Sci. 2014, 430, 1–5. [Google Scholar] [CrossRef]
- Yu, H.C.; Kang, H.X.; Jiao, Z.B.; Lü, G.X.; Bi, Y.P. Tunable photocatalytic selectivity and stability of Ba-doped Ag3PO4 hollow nanosheets. Chin. J. Catal. 2015, 36, 1587–1595. [Google Scholar] [CrossRef]
- Reunchan, P.; Umezawa, N. Sulfur and silicon doping in Ag3PO4. J. Phys. Chem. C 2015, 119, 2284–2289. [Google Scholar] [CrossRef]
- Cao, W.; Gui, Z.; Chen, L.; Zhu, X.; Qi, Z. Facile synthesis of sulfate-doped Ag3PO4 with enhanced visible light photocatalystic activity. Appl. Catal. B Environ. 2017, 200, 681–689. [Google Scholar] [CrossRef]
- Roobottom, H.K.; Jenkins, H.D.B.; Passmore, J.; Glasser, L. Thermochemical radii of complex ions. J. Chem. Educ. 1999, 76, 1570–1573. [Google Scholar] [CrossRef]
- Tao, R.; Yang, S.; Shao, C.; Li, X.; Li, X.; Liu, S.; Zhang, J.; Liu, Y. Reusable and flexible g-C3N4/Ag3PO4/Polyacrylonitrile heterojunction nanofibers for photocatalytic dye degradation and oxygen evolution. Acs Appl. Nano Mater. 2019, 2, 3081–3090. [Google Scholar] [CrossRef]
- Panthi, G.; Park, S.-J.; Chae, S.-H.; Kim, T.-W.; Chung, H.-J.; Hong, S.-T.; Park, M.; Kim, H.-Y. Immobilization of Ag3PO4 nanoparticles on electrospun PAN nanofibers via surface oximation: Bifunctional composite membrane with enhanced photocatalytic and antimicrobial activities. J. Ind. Eng. Chem. 2017, 25, 277–286. [Google Scholar] [CrossRef]
- Gangemi, C.M.A.; Ludici, M.; Spitaleri, L.; Randazzo, R.; Gaeta, M.; D’Urso, A.; Gulino, A.; Purrello, R.; Fragalà, M.E. Polyethersulfone mats functionalized with porphyrin for removal of para-nitroaniline from aqueous solution. Molecules 2019, 24, 3344. [Google Scholar] [CrossRef] [PubMed]
- Panthi, G.; Park, S.-J.; Kim, T.-W.; Chung, H.-J.; Hong, S.-T.; Park, M.; Kim, H.-Y. Electrospun composite nanofibers of polyacrylonitrile and Ag2CO3 nanoparticles for visible light photocatalysis and antibacterial applications. J. Mater. Sci. 2015, 50, 4477–4485. [Google Scholar] [CrossRef]
- Panthi, G.; Barakat, N.A.M.; Khalil, K.A.; Yousef, A.; Jeon, K.-S.; Kim, H.K. Encapsulation of CoS nanoparticles in PAN electrospun nanofibers: Effective and reusable catalyst for ammonia borane hydrolysis and dye photodegradation. Ceram. Int. 2013, 39, 1469–1476. [Google Scholar] [CrossRef]
- Wang, C.; Wang, J.; Zeng, L.; Qiao, Z.; Liu, X.; Liu, H.; Zhang, J.; Ding, J. Fabrication of electrospun polymer nanofibers with diverse morphologies. Molecules 2019, 24, 834. [Google Scholar] [CrossRef]
- Wang, Q.; Cui, J.; Li, G.; Zhang, J.; Li, D.; Huang, F.; Wei, Q. Laccase immobilized on a PAN/Adsorbents composite nanofibrous membrane for catechol treatment by a biocatalysis/adsorption process. Molecules 2014, 19, 3376–3388. [Google Scholar] [CrossRef]
- Anisimov, V.I.; Zaanen, J.; Andersen, O.K. Band theory and Mott insulators: Hubbard U instesd of Stoner. I. Phys. Rev. B 1991, 44, 943–954. [Google Scholar] [CrossRef]
- Zhang, W.; Liu, J.; Wu, G. Evolution of structure and properties of PAN precursors during their conversion to carbon fibers. Carbon 2003, 41, 2805–2812. [Google Scholar]
- Huang, G.L.; Zhu, Y.F. Enhanced photocatalytic activity of ZnWO4 catalyst via fluorine doping. J. Phys. Chem. C 2007, 111, 11952–11958. [Google Scholar] [CrossRef]
- Miller, L.M.; Vairavamurthy, V.; Chance, M.R.; Mendelsohn, R.; Paschalis, E.P.; Betts, F.; Boskey, A.L. In situ analysis of mineral content and crystallinity in bone using infrared micro-spectroscopy of the ν4 PO43− vibration. Biochim. Biophys. Acta 2001, 1527, 11–19. [Google Scholar] [CrossRef]
- Sifontes, Á.B.; Cañizales, E.; Toro-Mendoza, J.; Ávila, E.; Hernández, P.; Delgado, B.A.; Gutiérrez, G.B.; Díaz, Y.; Cruz-Barrios, E. Obtaining highly crystalline barium sulphate nanoparticles via chemical precipitation and quenching in absence of polymer stabilizers. J. Nanomater. 2015, 2015, 1–8. [Google Scholar] [CrossRef]
- Gomez, M.A.; Han, B.; Yao, S.; Chen, Y.; Li, S.; Zhang, D.; Wang, S.; Jia, Y. A new and improved synthesis method for the formation of ZnFe-CO3 and ZnFe-SO4 hydrotalcites free from impurities. Appl. Clay Sci. 2019, 181, 105215–105224. [Google Scholar]
- Mane, R.S.; Lee, W.J.; Pathan, H.M.; Han, S.H. Nanocrystalline TiO2/ZnO thin films: Fabrication and application to dye-sensitized solar cells. J. Phy. Chem. B 2005, 109, 24254–24259. [Google Scholar] [CrossRef] [PubMed]
- Yang, T.; Yang, H.; Zhen, S.J.; Huang, C.Z. Hydrogen-bond-mediated in situ fabrication of AgNPs/Agar/PAN electrospun nanofibers as reproducible SERS subrtrates. Acs Appl. Mater. Interfaces 2015, 7, 1586–1594. [Google Scholar] [CrossRef] [PubMed]
- Cao, W.R.; Chen, L.F.; Qi, Z.W. Microwave-assisted synthesis of Ag/Ag2SO4/ZnO nanostructures for efficient visible-light driven photocatalysis. J. Mol. Catal. A Chem. 2015, 401, 81–89. [Google Scholar] [CrossRef]
- Wang, D.H.; Jia, L.; Wu, X.L.; Lu, L.Q.; Xu, A.W. One-step hydrothermal synthesis of n-doped TiO2/C nanocomposites with high visible light photocatalytic activity. Nanoscale 2012, 4, 576–584. [Google Scholar] [CrossRef]
- Amato, E.; Diaz-Fernandez, Y.A.; Taglietti, A.; Pallavicini, P.; Pasotti, L.; Cucca, L.; Milanese, C.; Grisoli, P.; Dacarro, C.; FernandezHechavarria, J.M.; et al. Synthesis, characterization and antibacterial activity against Gram positive and Gram negative bacteria of biomimetically coated silver nanoparticles. Langmuir 2011, 27, 9165–9173. [Google Scholar] [CrossRef]
- Taglietti, A.; Fernandez, Y.A.D.; Elvio Amato, E.; Cucca, L.; Dacarro, G.; Grisoli, P.; Necchi, V.; Pallavicini, P.; Pasotti, L.; Patrini, M. Antibacterial activity of glutathione-coated silver nanoparticlesagainst Gram positive and Gram negative bacteria. Langmuir 2012, 28, 8140–8148. [Google Scholar] [CrossRef]
- Li, Y.; Zhang, W.; Neu, J.; Chen, Y. Mechanism of photogenerated reactive oxygen species and correlation with the antibacterial properties of engineered metal-oxide nanoparticles. Acs Nano 2012, 6, 5164–5173. [Google Scholar] [CrossRef]
- Kiwi, J.; Nadtochenko, V. Evidence for the mechanism of photocatalytic degradation of the bacterial wall membrane at the TiO2 interface by ATR-FTIR and laser kinetic spectroscopy. Langmuir 2005, 21, 4631–4641. [Google Scholar] [CrossRef] [PubMed]
- Jo, W.J.; Jang, J.W.; Kong, K.; Kang, H.J.; Kim, J.Y.; Jun, H.; Parmar, K.P.S.; Lee, J.S. Phosphate doping into monoclinic BiVO4 for enhanced photoelectrochemical water oxidation activity. Angew. Chem. Int. Ed. 2012, 51, 3147–3151. [Google Scholar] [CrossRef] [PubMed]
- Kung, M.-L.; Tai, M.-H.; Lin, P.-Y.; Wu, D.-C.; Wu, W.-J.; Yeh, B.-W.; Hung, H.-S.; Kuo, C.-H.; Chen, Y.-W.; Hsieh, S.-L. Silver decorated copper oxide (Ag@ CuO) nanocomposite enhances ROS-mediated bacterial architecture collapse. Colloids Surf. B 2017, 155, 399–407. [Google Scholar] [CrossRef] [PubMed]
- Hombach, M.; Zbinden, R.; Böttger, E.C. Standardisation of disk diffusion results for antibiotic susceptibility testing using the sirscan automated zone reader. BMC Microbiol. 2013, 13, 225. [Google Scholar] [CrossRef]
- O’Toole, D.K. Methods for the direct and indirect assessment of the bacterial content of milk. J. Appl. Bacteriol. 1983, 55, 187–201. [Google Scholar] [CrossRef]
- IBM. SPSS Statistics for Windows, Version 24.0.; IBM Corp: Armonk, NY, USA, 2016. [Google Scholar]

© 2020 by the authors. Licensee MDPI, Basel, Switzerland. This article is an open access article distributed under the terms and conditions of the Creative Commons Attribution (CC BY) license (http://creativecommons.org/licenses/by/4.0/).
Share and Cite
Panthi, G.; Hassan, M.M.; Kuk, Y.-S.; Kim, J.Y.; Chung, H.-J.; Hong, S.-T.; Park, M. Enhanced Antibacterial Property of Sulfate-Doped Ag3PO4 Nanoparticles Supported on PAN Electrospun Nanofibers. Molecules 2020, 25, 1411. https://doi.org/10.3390/molecules25061411
Panthi G, Hassan MM, Kuk Y-S, Kim JY, Chung H-J, Hong S-T, Park M. Enhanced Antibacterial Property of Sulfate-Doped Ag3PO4 Nanoparticles Supported on PAN Electrospun Nanofibers. Molecules. 2020; 25(6):1411. https://doi.org/10.3390/molecules25061411
Chicago/Turabian StylePanthi, Gopal, Md. Mehedi Hassan, Yun-Su Kuk, Ji Yeon Kim, Hea-Jong Chung, Seong-Tshool Hong, and Mira Park. 2020. "Enhanced Antibacterial Property of Sulfate-Doped Ag3PO4 Nanoparticles Supported on PAN Electrospun Nanofibers" Molecules 25, no. 6: 1411. https://doi.org/10.3390/molecules25061411
APA StylePanthi, G., Hassan, M. M., Kuk, Y.-S., Kim, J. Y., Chung, H.-J., Hong, S.-T., & Park, M. (2020). Enhanced Antibacterial Property of Sulfate-Doped Ag3PO4 Nanoparticles Supported on PAN Electrospun Nanofibers. Molecules, 25(6), 1411. https://doi.org/10.3390/molecules25061411
